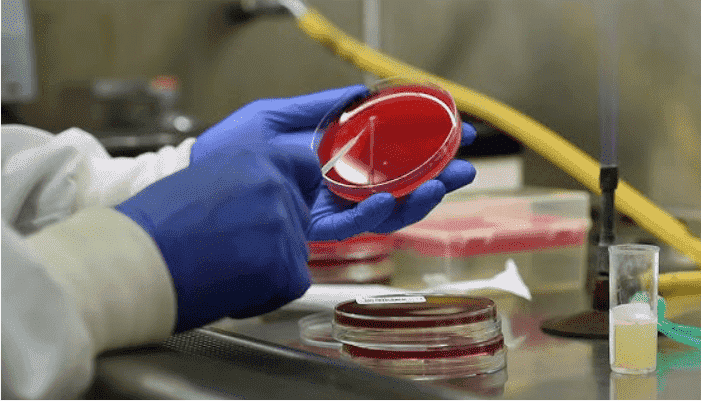

Urine Culture (Clean Catch): Purpose, Collection, and Results Explained
Urine Culture
Also Known As:
- CMVS Culture
- Midstream Urine Culture
- Foley Catheter Urine Culture
Purpose of the Test
This test is used to detect and isolate bacteria that cause urinary tract infections (UTIs). A properly collected clean-catch sample is essential to avoid contamination and ensure reliable results.
Patient Care & Preparation
Patients should be instructed on the clean-catch technique. Wash hands thoroughly. Then clean the genital area with four soapy sponges in a downward motion, followed by one water-moistened sponge. Use each sponge once only. Begin urinating and discard the first 30 mL (1 oz), then collect the midstream urine in a sterile container without touching the inside.
Specimen Collection
- Type: Midstream random urine sample
- Container: Sterile plastic tube or specimen cup
- Timing: Early morning samples are best as they yield higher bacterial counts
Storage Instructions
Refrigerate the sample if it cannot be processed within 2 hours. Use a preservative tube if refrigeration is not available.
Reason for Sample Rejection
Samples left at room temperature for more than 2 hours may have overgrown bacteria and produce false-positive results.
Turnaround Time
- Initial report: Available within 24 hours
- Final report: Typically ready within 48 hours depending on organism growth
Reference Range
No growth is considered normal. A count of ≥105 CFU/mL indicates significant bacteriuria.
Methodology
Urine is quantitatively cultured using a calibrated loop (0.001 mL) on agar plates. Growth of ≥103 CFU/mL may also be clinically relevant depending on symptoms and collection quality.
Use
To detect and identify pathogenic bacteria in suspected urinary tract infections, especially in symptomatic patients, pregnant women, or immunocompromised individuals.
Limitations
- Contamination during collection can lead to false positives
- Routine methods may miss low-level bacteriuria (<1000 CFU/mL)
- Positive culture with >2 organisms suggests contamination
- False-negatives can occur if the patient is on antibiotics
Additional Information
- Women using diaphragms and spermicides are at higher risk for UTIs
- In elderly or institutionalized patients, routine screening is recommended
- Gram stain or slide centrifuge can enhance early detection
- Foley catheter samples with high colony counts may indicate colonization, not infection
Best Practices
- Always label samples with patient details, time, and date of collection
- Educate patients on proper collection to reduce false results
- If two or more organisms are grown, recollect a clean sample for accurate diagnosis
References
- Stamm WE, Johnson JR, Hooton TM. “Urinary Tract Infections,” J Infect Dis
- Olson ML, Shanholtzer CJ. “Urine Screening Methods,” Am J Clin Pathol, 1991
- Williams JD. “UTI Diagnostic Criteria,” Infection, 1992
- Jacobs, Demott, Finley et al. “Laboratory Test Handbook,” Lexi-Comp Inc, 1994